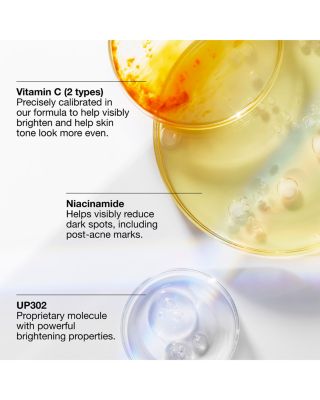
Even Better Clinical Dark Spot Clearing Serum with Vitamin C 1.7 oz.

SDD=BOPS=Bath & BodyCoatsEye MakeupFace MakeupFragranceGift SetsGift with PurchaseJacketsLipsSkin CareSun CareTools & BrushesVestsWatches1.STATE3.1 Phillip Lim4th & Reckless7 For All Mankind107111SKIN525 AmericaA.L.C.A.W.A.K.E. MODEAbyssAccouchéeAcqua di ParmaAddison Bayadidas by Stella McCartneyAdina ReyterAdore MeAdrianna By Adrianna PapellAdrianna PapellAdrianna Papell PlusAdrienne LandauAERINAesopAeydeAFRMAGAGLAGOLDEAgua BenditaAidan MattoxAkroAKTAlaiaAlberto AmatiAlberto MilaniALCAldo MartinsAlex MillAlexander WangalexanderwangAlexandre BirmanAlexis BittarAlgenistAlice and OliviaALLSAINTSALOHA CollectionALORAlternaALTERNATIVEAltesse StudioAltuzarraAlémaisAmazonAme & LuluAmerican VintageAMOREPACIFICAmsaleAmurAna LuisaAnabel AramAnabela ChanAnastasia Beverly HillsAncient Greek SandalsAndieAndre AssousAndrew MarcAnine BingAnna SuiAnne de SoleneANNETTE FERDINANDSEN DESIGNANNI LUAnuaAP BEAUTYAPAYAAPL Athletic Propulsion LabsApparisAQUAAQUA ATHLETICSAquataliaAquazzuraAREAArea StarsArgento VivoARgENTUMArlottaArmaArmaniAS by DFAshAsicsASKK NYASTR the LabelAtelier VersaceATMATWATERaudio-technicaAugustinus BaderAUGUSTNOAAUR OCEÀAutryAvec Les FillesAviator NationAYA MUSEB-low the Beltb.tempt'd by Wacoalba&shBABORBabylettoBadgley MischkaBagatelleBaggalliniBalenciagaBalmainBao Bao Issey MiyakeBarbourBardotBAREFOOT DREAMSbareMineralsBarr-Co.Bask SuncareBAUBLEBARBaume & MercierBCBGMAXAZRIABea BongiascaBeach RiotBeatsBeats by Dr. DreBeats by DreBeautifectBeauty StatbeautyblenderBECCA® by Rebecca VirtueBedHead PajamasBelifBellBella DahlBen AmunBenamorBentgoBernardoBetsy & AdamBeyond YogaBilly TBinge KnittingBiologique RechercheBirkenstockBits & BowsBlack HaloBlack Suede StudioBLANKNYCBleu Rod BeattieBloomingdale'sBloomingdale's Fine CollectionBluebellaBobbi BrownBogner Fire + IceBoll & BranchBond No. 9 New Yorkbond-eyeBorgheseBoseBOSSBottega VenetaBRABARBrandon MaxwellBrane AudioBREDABric'sBright SwimwearBriogeoBRONX AND BANCOBTB Los AngelesBugabooBulovaBumble and bumbleBurberryBusayoButtah by Dorion RenaudBVLGARIBy Adina EdenBY TERRYBYREDOBÉISC by Bloomingdale's CashmereC.O. BigelowCADDISCala de la CruzCalistaCall it By Your NameCallistaCalvin KleinCalypso St. BarthCamillaCanada GooseCanopyCapittanaCapucine De WulfCara CaraCaresteCarolina HerreraCaroline RoseCarolyn Rowan AccessoriesCarreraCartierCartolinaCastañerCeCeCELINECentral Park WestCeremoniaCHANELChantecailleChantelleCharlotte TilburyChiara Boni La Petite RobeChimiChinti & ParkerChloéChristian DiorChristian LouboutinChristophe RobinChristyCiao LuciaCinq à SeptCinzia RoccaCISSACitizenCitizens of HumanityClare V.ClarinsCliniqueClé de Peau BeautéCOCOACHCoastCOGCole HaanCommandoComme Des Garcons PLAYConiglio Palm BeachConverseCoolaCordovaCosabellaCotopaxiCotton CitizenCowshedCozy EarthCozylandCREEDCrivelliCrocsCult GaiaCUUPCuyanaCXCCybexCynthia RowleyDagne DoverDame ProductsDani MarieDanielle GuizioDavid WebbDavid YurmanDawn LevyDe Beers ForevermarkDear DahliaDecortéDelsey ParisDEMARSONDeMellierDenimistDenonDepartureDerek Lam 10 CrosbyDERM iNSTITUTEDesmond & DempseyDeux par DeuxDIARRABLUDinh VanDIORDippin' Daisy'sDIPTYQUEDita Von TeeseDL1961Dolce & GabbanaDolce VitaDominique IntimatesDonald PlinerDonna KaranDonna Karan New YorkDonna MorganDR. BARBARA STURMDr. CeuracleDr. Dennis Gross SkincareDr. Diamond's MetacineDr. Lara DevganDr. MartensDragon DiffusionDress the PopulationDriftwoodDrowsyDrybarDS & DURGADysonEB DenimEberjeyEchoEcollineEddyEdiktedEF CollectionEighth DayEileen FisherEileen Fisher PetitesEileen Fisher PlusEileen WestElanELEMISElephantitoElie TahariEliza JELLE CollectionElliattELODIE THE LABELElomiEmi JayEmporio ArmaniEn SaisonEnglish FactoryEqulibErbavivaErdemEric JavitsErno LaszloEscentric MoleculesEskerEssentiel AntwerpEstelle PlusEstée LauderEtat Libre d'OrangeEtho MariaEtroEttikaEugenia KimEVE LOMEX NIHILOEXTENSIBLEF&W StyleFaber-CastellFabiana FilippiFAEFahertyFalkeFARM RioFarmhouse PotteryFashion FormsFASHION-SZN CURVEFeeturesFendiFERRAGAMOFerrariFHI HeatFifteen TwentyFilterbabyFirst Aid BeautyFitFlopFlamingo EstateFleur du MalFlora NikroozFloral StreetFoot PetalsFOPEFOREFOREOFormeFossilFoxcroftFoxcroft PlusFRAASFRAMEFrances ValentineFranck MullerFreda SalvadorFrederique ConstantFree PeopleFREECITYFRENCH CONNECTIONFrench KnotFretteFrida BabyFrédéric MalleG-ShockG.H.BASSGa.Ma Italy ProfessionalGANNIGarminGAVAZZENIGeneration LoveGentle Souls by Kenneth ColeGeorg JensenGerard DarelghdGhost LondonGiambattista ValliGianvito RossiGigi ClozeauGingerlilyGINIAGiuseppe ZanottiGivenchyGlorioGOHAR WORLDGolaGOLDBERGHGolden GooseGoldfaden MDGood AmericanGorskiGottexGraciaGucciGuerlainGuest in ResidenceGurhanGustBusterHABIBI NYHairmaxHalfdaysHALSTONHamiltonHanky PankyHanroHappy SocksHartmannharuharu wonderHat AttackHATCH CollectionhavaianasHEARTS ON FIREHeavenHeaven MayhemHeimishHeiress Beverly HillsHelmut LangHelsiHemant and NanditaHEREUHERMÈSHernoHERVÉ by Hervé LégerHervé LégerHeysHigh Heel JungleHigherDOSEHill House HomeHiSOHOBBS LONDONHOKAHommeGirlsHoneydewHoneyloveHOORSENBUHSHourglassHouse of BoHudsonHudson Park CollectionHUEHugo BossHunkemöllerHunterHunza GHyejaHYER GOODSHyggeeIGK HairIl BisonteIleana MakriIles FormulaIlios LightingIlse JacobsenIluminageIn Bloom by JonquilIndego AfricaINFINIMENT COTY PARISIngrid & IsabelInitio Parfums PrivésIPPOLITAIRENE FORTEIROIsabel MarantISDINIssey MiyakeITEM m6IZIPIZIJaboneria MarianellaJack BlackJack RogersJACKIE MACK DESIGNSJACQUEMUSJane PostJason MarkkJason Wu CollectionJBLJeffrey CampbellJenni KayneJennifer BehrJennifer ZeunerJenny PackhamJETSJil SanderJimmy ChooJLUXLABELJo Malone LondonJocelynJoe's JeansJohanna OrtizJOHN HARDYJohn VarvatosJohnny WasJolieJORDEJoshua SandersJournelleJoyluxJUAN DE DIOSJuliette Has A GunJumper 1234JUNAJunk Food ClothingJVNJW AndersonK-WayK.JacquesKAHINDOKaren KaneKARL LAGERFELDKARL LAGERFELD PARISKat BurkiKate Bartonkate spade new yorkKatie KimeKay UngerKAYUKazuriKendra ScottKenneth ColeKenneth Jay LaneKerri RosenthalKEVYN AUCOINKHAITEKiehl's Since 1851KIKI DE MONTPARNASSEKILIAN PARISKind PatchesKIPKitschKnixwearKOBAKobi HalperinKOKO + MASONKreweKsubiKuleKURT GEIGER LONDONKutniaKyi KyiL'AGENCEL'IDEEL*SpaceL. KleinLa BlancaLa Bonne BrosseLa CanadienneLa DoubleJLa Fée MaraboutéeLa MerLa Petite RobeLa PrairieLack of ColorLafayette 148 New YorkLAFCOLAGOSLAMARQUELANALANCERLancômeLanvinLarroudéLaura MercierLaurenLAUREN MOSHILe LaboLe MystèreLe SpecsLele SadoughiLELET NYLEO LINLeonor GreylLESETLevi'sLiffnerLIKELYLILISLilly PulitzerLILYSILKLine & DotLionessLisa Marie FernandezLittle Words ProjectLIULILiv FosterLive UnlimitedLiverpool Los AngelesLiverpool Los Angeles PlusLiving ProofLOCKS & MANELoeffler RandallLoevenichLoeweLolliaLondontownLongchampLonginesLOOK OPTICLost and WanderLove TokenLoveShackFancyLSPACELucky & CocoLucky in LoveLucy ParisLUMINA NRGLunyaLUVEELuvumLuxelyLyla GrantLysséLyssé PlusM.M.LaFleurMac DuggalMackageMadewellMADLUVVMagic HourMagicsuitMAISON de SABRÉMaison Francis KurkdjianMaison Louis MarieMaison MargielaMajeMajestic FilaturesMalaiMALIN and GOETZMalinaMalone SouliersManceraMansur Gavrielmar Y solMarc CainMarc Fisher LTD.MARC JACOBSMarc New YorkMarco BicegoMarellaMARGAUXMARIA TASHMarie OliverMarina BMarina RinaldiMarine LayerMario BadescuMARIONMARION PARKEMarkarianMarniMason PearsonMatiere PremiereMatoukmaudeMaui JimMax MaraMax Mara StudioMAX&Co.MaximilianMCMMcQueenMDSolarSciencesMediAnswerMeira TMelixirMemo ParisMessikaMetaMeUndiesMichael AramMichael KorsMichael Kors CollectionMICHAEL LAURENMICHAEL Michael KorsMICHELEMIDOMikomilk + honeyMILLYMIND GAMESMinnie RoseMint VelvetMiraclesuitMiriam QuevedoMiseno JewelryMisookMiss CircleMissoniMiu MiuModern PicnicMOLOCOMolton BrownMommy MattersMonclerMonique LhuillierMontaleMontblancMoon & MeadowMoon BootMoon RiverMoose KnucklesMoroccanoilMoschinoMotetteMOTHERMount LaiMovadoMuglerMVMTMZ SKINMZ WALLACEM·A·CNadriNAGHEDINail ReformationNaked WardrobeNaked WolfeNancy YangNarciso RodriguezNARSNasty GalNatoriNatori EditNatura BisséNatureLab TOKYONeedle & ThreadNegativeNEST New YorkneuLashNew BalanceNew EraNew WaveNIANIC+ZOENIC+ZOE PlusNicholasNightcapNikeNina GordonNippiesNixonNoble PanaceaNOCTURNENom MaternityNONCHALANT LABELNookieNorma KamaliNorthern ClassicsNour HammourNuFaceNVLTNYDJNYDJ PlusNZT BY NIC+ZOEOak EssentialsOakleyOh La La CheriOLAPLEXOliver PeoplesOlivia BurtonOluraOmoroviczaOnOn GossamerONCEPTOniaOraOradinaORIBEOrtigia SiciliaOrvedaOryza LabOscalitoOscar de la RentaOSEA MalibuOtis BatterbeeOttoman HandsP448PAIGEPAIGELAURENPalmaceaPALOMA BARCELÓParallelleParfums de MarlyPasquale BruniPatBOPatchologyPATOUPaul GreenPaul SmithPDPAOLAPeachausPearl Octopuss.yPeixotoPenhaligon'sPepperPerfect MomentperfectwhiteteePerricone MDPersolPesericoPeter Thomas RothPetite PlumePhase EightPHILIP BPHILIPP PLEINPhilips SonicarePhillips HousePHYSICIAN ENDORSEDPINKOPinsyPIRANESIPistolaPJ SalvagePlatinum inspired by Solange FerrariniPlayStation x Yinka IloriPLEATS PLEASE ISSEY MIYAKEPointPolo Ralph LaurenPomellatoPOOLSIDEPort De BrasPoupette St. BarthPQ SwimPradaPraktiPratesiPre-Owned BreguetPre-Owned BreitlingPre-Owned BvlgariPre-Owned CartierPre-Owned GoyardPre-Owned HERMÈSPre-Owned IWC SchaffhausenPre-Owned OmegaPre-Owned RolexPre-Owned Van Cleef & ArpelsPrincetonPrint FreshProenza SchoulerProenza Schouler White LabelProfile by GottexPucciPUMAPURE MAMAPuritoPyunkang YulR and CoRabanneRachel GilbertRachel ReidRADOrag & boneRahiRailsRainsRalph LaurenRamy BrookRay-BanRaymond WeilRE/DONERebecca MinkoffRed CarterReebokReformationREISSRene CaovillaRescueMDRetrofeteRHODERhoneRipe MaternityRo&ZoRoberto CavalliRoberto CoinRoberto DemeglioRobin PicconeRodialROJArokhRonny KoboRose IncRosebud WomanRosetta GettyROTATERothy'sRoxanne AssoulinROYCE New YorkRudes DenimRudsakRue SophieRya CollectionRÓHERéViveSachajuanSafelySafiyaaSaint ArtSAINT LAURENTSalomonSALONISalvatore FerragamoSam EdelmanSAM.SamsoniteSan Diego Hat CompanySanctuarySandroSantoniSantorelliSaranoniSAU LEESave The DuckSCHUTZSeaSeasalt CornwallSecret MissionSeiko WatchSelf-PortraitSENTALERSergio HudsonSeroVitalSFERRAShahla KarimishaishaishaiSharkShashiShedrainShinolaShiseidoSHONA JOYShoshannaShy CreationSigerson MorrisonSigma BeautySignificant OtherSIMKHAISimone PerelesimplehumanSingle ThreadSioniSisley ParisSix FiftySK-IISkarlett BlueSKIMSSkin GymSkinMedicaslipSLVRLAKESmile MakersSobel Skin RxSofia CashmereSoia & KyoSol & Selenesolar eclipseSoli & SunSolid & StripedSonosSONYSophia WebsterSorelSPANX®SperrySplendidSplits59St. JohnStancestandards & practicesSTARSKINSTAUDStella McCartneyStellahStemsSterling ForeverSTEVE MADDENStinaa.JStoney Clover LaneStrathberryStuart WeitzmanSulwhasooSummer CampSUNDAY RILEYSunshine 79SurellSusana MonacoSusanna ChowSUZANNE KALANSwarovskiSweaty BettySweedSweet WinkSydney EvanT TahariT3TABTABACARUTadashi ShojiTAG HeuerTahariTalking TablesTAN-LUXETC Fine IntimatesTed BakerTELETIESTemple St. ClairTerezTeri Jon by Rickie FreemanTevaThe Good JourneyTHE GREAT.The Hair EditThe KooplesThe Lulo ProjectThe North Face®TheiaTHEMOIRèTheoryTherabodyThink RoylnThistle and SpireThomas KosmalaThree DotsTiare HawaiiTielaTiffany & Co.TimexTissotTKEESTOCCINTod'sTom FordTommy BahamaTOMSTory BurchTOTEMETotesTouchlandTOVETravelproTRESSÉTrish McEvoy®TRUE & CO.TumiTYPEBEAU BeautyUchinoUGG®UlikeUnfortunate PortraitUngaroUniversal StandardUNOde50UrangUwila WarriorV FraasV. ChapmanVacationVagabond ShoemakersValentinoValentino GaravaniVALIMAREVan Cleef & ArpelsVANESSA BRUNOVansVarleyVEE COLLECTIVEVEJAVelvetVelvet by Graham & SpencerVERBVero ModaVeronica BeardVeronique GabaiVersaceVersace Jeans CoutureVersus VersaceViBi VeneziaVictoria BeckhamVictoria Beckham BeautyVida GlowViktor&RolfVilhelm ParfumerieVinceVINCE CAMUTOVineyard VinesVinoirVintage HavanaVintner's DaughterVirtueViX Paula HermannyVOLO BeautyVoluspaVRAIVuoriWacoalWaimariWalters FaithWandlerWARDROBE.NYCWarehouseWarp + WeftWaterfordWatskinWAYBWAYFWeekend Max MaraWest OfWhistlesWildfangWillowWILT ClothingWinsor & NewtonWOLFWolfordWoxerWWAKEWYLYSXERJOFFXscapeYinka IloriYinka Ilori x Bloomingdale'sYinka Ilori x New EraYoéYummieYves DurifYves Saint LaurentYvonne LéonZac PosenZadig & VoltaireZEGNAZodiacZoe LevZoë ChiccoZYDOGift with PurchaseLoyallist Points OffersOffersSale & ClearanceSpecial Offer0|49.9950|100100|250250|500500|-120_PERCENT_ off & moreBeauty & CosmeticsJewelry & AccessoriesWomenBelted/WrapFaux FurParkaPufferRain JacketShearling JacketsTeddyVestCotton/Cotton BlendDownFaux FurNylonShearlingSherpaMenUnisexWomenShortMidCropped
- GET YOUR ORDER TODAY with Curbside or In-Store Pickup, or Same Day Delivery. SHOP NOW
- Loyallists get a $25 Reward (5,000 points) for every $100 spent on select items. Ends 12/16. INFO
- Online 2 days only! Save 40–70% on select coats, winter accessories, boots & cashmere. Ends 12/13. SHOP NOW
- INCREDIBLE DIAMOND DEAL: 10-carat diamond tennis necklace in 14K white or yellow gold, $9,999 (reg. $24,000). Ends 12/16. SHOP NOW
- GET YOUR ORDER TODAY with Curbside or In-Store Pickup, or Same Day Delivery. SHOP NOW
{
"isNavMockHeader": false,
"isNavMockFooter": false,
"version": "2.412.3"
}